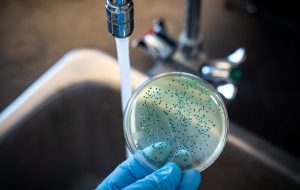
حصبه؛ علائم، عوارض، روش تشخیص، درمان و پیشگیری حصبه؛ علائم، عوارض، روش تشخیص، درمان و پیشگیری

حصبه؛ علائم، عوارض، روش تشخیص، درمان و پیشگیری
حصبه یا تب تیفوئید عفونتی باکتریایی است و میتواند بسیار خطرناک یا حتی کشنده باشد. این عفونت معمولا از طریق غذا و آب آلوده منتقل میشود، به همین دلیل بهراحتی قابلپیشگیری است. حصبه بیشتر در مناطقی شیوع دارد که افراد کمتر دستشان را میشویند. برای آشنایی با علائم این بیماری، روشهای پیشگیری از آن و
حصبه یا تب تیفوئید عفونتی باکتریایی است و میتواند بسیار خطرناک یا حتی کشنده باشد. این عفونت معمولا از طریق غذا و آب آلوده منتقل میشود، به همین دلیل بهراحتی قابلپیشگیری است. حصبه بیشتر در مناطقی شیوع دارد که افراد کمتر دستشان را میشویند. برای آشنایی با علائم این بیماری، روشهای پیشگیری از آن و درمانش با ما همراه باشید.
حصبه چیست؟
این بیماری عفونتی حاد است که بر اثر باکتریوم سالمونلا تیفیموریوم ایجاد میشود. این باکتری در رودهها و جریان خون انسان زندگی میکند و فقط با تماس مستقیم فرد با مدفوع فرد بیمار منتقل شود. هیچ حیوانی ناقل این بیماری نیست و تنها بین انسانها منتقل میشود.
اگر بیماری حصبه درمان نشود، برای ۲۰درصد مبتلایان کشنده خواهد بود. با درمان، این عدد به کمتر از ۴درصد میرسد. باکتری ایجادکننده بیماری از دهان وارد میشود و طی مدت ۱ تا ۳ هفته به رودهها راه مییابد. پس از آن، مسیر خود را از دیواره روده به جریان خون باز میکند. این باکتری خود را از طریق جریان خون به سایر بافتها و اعضای بدن میرساند. سیستم ایمنی بدن قادر نیست بهخوبی با این باکتری مقابله کند.
روشهای تشخیص باکتری نمونهبرداری از خون، مدفوع، ادرار و مغز استخوان هستند. حصبه بهندرت در کشورهای پیشرفته دیده میشود و بیشتر در کشورهای در حال توسعه شیوع دارد. سالانه ۲۱میلیون نفر به این بیماری مبتلا میشوند و ۲۰۰،۰۰۰ نفر جان خود را از دست میدهند.
علائم حصبه
علائم اولیه بیماری
- تبی که ابتدا کم است، اما هر روز بیشتر میشود و حتی به ۴۰٫۵ درجه سانتیگراد میرسد؛
- ضعف و خستگی مفرط؛
- سردرد؛
- درد ماهیچه؛
- عرقکردن؛
- سرفه خشک؛
- ازدستدادن اشتها و کاهش وزن؛
- درد شکمی؛
- اسهال یا یبوست؛
- جوش پوستی؛
- معده بهشدت متورم.
علائم ثانویه
در صورت درماننشدن، این علائم ظاهر میشوند:
- توهم؛
- بیحس و بیانرژی بودن، درازکشیدن با چشمانی نیمهبسته.
در این حالت، امکان بروز عارضههای کشنده وجود دارد. ممکن است علائم بعضی افراد ۲ هفته پس از کاهش تب دوباره بازگردند.
انتقال حصبه
باکتری ایجادکننده این بیماری در مدفوع و گاهی در ادرار افراد مبتلا وجود دارد. اگر فرد مبتلا به حصبه بعد از دستشویی رفتن دستش را بهخوبی نشسته باشد و با غذای فرد سالم تماس داشته باشد، ممکن است فرد سالم هم به حصبه مبتلا شود.
در کشورهای در حال توسعه، حصبه شیوع بیشتری دارد و افراد با نوشیدن آب آلوده یا تماس مستقیم با فرد بیمار به این بیماری مبتلا میشوند. همچنین شستن میوه و سبزیجات با آب آلوده نیز میتواند باعث انتقال بیماری شود. این باکتری میتواند هفتهها در آب یا فاضلاب خشک زنده بماند.
ناقلان حصبه
حتی پس از درمان با آنتیبیوتیک، ۳ تا ۵درصد افراد بهبودیافته میتوانند ناقل بیماری باشند. این افراد که «ناقل مزمن» نامیده میشوند، اصلا علائم ابتلا به حصبه را ندارند، اما همچنان این باکتری در مدفوعشان وجود دارد و میتوانند دیگران را آلوده کنند.
چه افرادی در معرض خطر آلودگی قرار دارند؟
این بیماری در هند، جنوب شرقی آسیا، آفریقا و آمریکای جنوبی بسیار شایع است. در سراسر جهان، کودکان بیشتر در معرض ابتلا به این بیماری قرار دارند. با وجود این، در مقایسه با بزرگسالان دچار علائم خفیفتری میشوند.
برای افرادی که در مناطقی با شیوع بالای حصبه زندگی نمیکنند، این عوامل باعث افزایش خطر ابتلا میشوند:
- سفر به مناطقی با شیوع بالای حصبه؛
- کارکردن بهعنوان میکروبیولوژیست بالینی در زمینه باکتری سالمونلا تایفی؛
- تماس نزیک با کسی که بیمار است یا بهتازگی به حصبه مبتلا شده؛
- نوشیدن آبی که با فاضلاب آلوده به باکتری حصبه تماس داشته است.
عارضههای ناشی از حصبه
خونریزی یا سوراخ رودهای یکی از جدیترین عوارض حصبه شدید است که معمولا در هفته سوم بیماری ایجاد میشود. در این حالت، روده کوچک یا بزرگ سوراخ و محتویات آن وارد شکم میشود. این امر باعث درد شکمی شدید، تهوع، استفراغ و عفونت خونی میشود. این عارضه جدی به درمان و مراقبت فوری نیاز دارد.
دیگر عارضههای احتمالی که کمتر شایع هستند، عبارتاند از:
تشخیص بیماری حصبه
پس از ورود بیماری حصبه به بدن، باکتریها توسط گلبولهای سفید به کبد، طحال و مغز استخوان میروند، در این مکانها تکثیر و دوباره وارد جریان خون میشوند. افراد مبتلا دچار علائمی مانند تب میشوند. باکتری به صفرا و بافت لنفی رودهها حمله میکند و با شدت بیشتری تکثیر میشود. باکتری وارد مسیر رودهها میشود و میتواند از طریق آزمایش مدفوع شناسایی شود. اگر جواب این آزمایش قطعی نباشد، نمونه خون یا ادرار نیز میتوانند برای تشخیص بیماری به کار روند.
درمان حصبه
تنها روش مؤثر برای درمان این بیماری استفاده از آنتیبیوتیک است. معمولا برای درمان حصبه از سیپروفلوکسین و سفتریاکسون استفاده میشود. علاوه بر آنتیبیوتیک، مهم است که فرد بیمار آب کافی بنوشد.
اگر رودهها سوراخ شوند، جراحی هم لازم خواهد بود.
پیشگیری
نوشیدن آب تمیز و مطمئن و رعایت بهداشت در پیشگیری از ابتلا به حصبه نقش مهمی دارند. در کشورهای در حال توسعه، دستیابی به این موارد میتواند دشوار باشد، به همین دلیل بعضی متخصصان بهترین روش برای پیشگیری از این بیماری را واکسیناسیون میدانند.
واکسنها
دو نوع واکسن برای این بیماری وجود دارد:
- نوعی که تنها ۱ دوز دارد و باید حداقل ۱ هفته پیش از مسافرت به مکانهایی با شیوع حصبه تزریق شود؛
- نوعی که بهشکل ۴ کپسول خوراکی ارائه میشود و این ۴ کپسول باید یک روز در میان خورده شوند.
هیچکدام از این واکسنها تأثیر ۱۰۰درصدی ندارند. همچنین ایمنی واکسنها پس از مدتی کاهش مییابد و باید تجدید شوند. با توجه به اینکه استفاده از واکسن ایمنی کامل ایجاد نمیکند، این اقدامات در برابر خطر ابتلا به حصبه از شما محافظت خواهند کرد:
- دستهای خود را بشویید. شستن مداوم دست با آب و صابون بهترین روش برای کنترل عفونت است. باید پیش از خوردن و پختن غذا و پس از رفتن به دستشویی دستهای خود را بشویید. هنگامی که آب در دسترس نیست، از محلولهای الکلی ضدعفونی دست استفاده کنید.
- از نوشیدن آب تصفیهنشده خودداری کنید. آب آشامیدنی آلوده یکی از مشکلات بزرگ مناطقی است که حصبه در آنها بسیار شایع است. به همین دلیل بهتر است فقط از آبهای عرضهشده در بطری و نوشیدنیهای گازدار بستهبندیشده استفاده کنید. در این شرایط آب گازدار از آب غیرگازدار مطمئنتر است. از نوشیدنیهای بدون یخ استفاده کنید. برای مسواکزدن از آب بطری استفاده کنید و در حمام از بلعیدن آب اجتناب کنید.
- از میوهها و سبزیجات خام استفاده نکنید. ممکن است محصولات خام در آب آلوده شسته شده باشند، بنابراین از خوردن میوهها و سبزیجاتی که نمیتوانید پوستشان را بکنید اجتناب کنید، مخصوصا کاهو. برای اطمینان کامل، بهتر است هیچ غذای خامی مصرف نکنید.
- غذاهای گرم مصرف کنید. از مصرف غذاهایی که در دمای اتاق تهیه میشوند خودداری کنید. غذاهای بسیار داغ ایدئال هستند. سعی کنید از خرید غذا از غذافروشیهای خیابانی اجتناب کنید.
سخن پایانی
حصبه میتواند یکی از عفونتهای باکتریایی پرخطر باشد و سالانه افراد زیادی را در کشورهای در حال توسعه مبتلا میکند. مهمترین مشخصههای این بیماری جوش پوستی و تب بسیار شدید هستند، اما در صورت شدتگرفتن بیماری، احتمال سوراخشدن دیواره روده یا حتی مرگ نیز وجود دارد. این بیماری با آب و غذای آلوده منتقل میشود و با آنتیبیوتیکها درمانشدنی است، اما بهتر است با مشاهده علائم اولیه فوری به پزشک مراجعه و درمان را آغاز کنید.
آموزش مجازی مدیریت عالی حرفه ای کسب و کار Post DBA+ مدرک معتبر قابل ترجمه رسمی با مهر دادگستری و وزارت امور خارجه | آموزش مجازی مدیریت عالی و حرفه ای کسب و کار DBA+ مدرک معتبر قابل ترجمه رسمی با مهر دادگستری و وزارت امور خارجه | آموزش مجازی مدیریت کسب و کار MBA+ مدرک معتبر قابل ترجمه رسمی با مهر دادگستری و وزارت امور خارجه |
![]() مدیریت حرفه ای کافی شاپ | ![]() حقوقدان خبره | ![]() سرآشپز حرفه ای |
آموزش مجازی تعمیرات موبایل | ![]() آموزش مجازی ICDL مهارت های رایانه کار درجه یک و دو | آموزش مجازی کارشناس معاملات املاک_ مشاور املاک |
برچسب ها :
ناموجود- نظرات ارسال شده توسط شما، پس از تایید توسط مدیران سایت منتشر خواهد شد.
- نظراتی که حاوی تهمت یا افترا باشد منتشر نخواهد شد.
- نظراتی که به غیر از زبان فارسی یا غیر مرتبط با خبر باشد منتشر نخواهد شد.



آموزش مجازی مدیریت عالی و حرفه ای کسب و کار DBA









ارسال نظر شما
مجموع نظرات : 0 در انتظار بررسی : 0 انتشار یافته : ۰